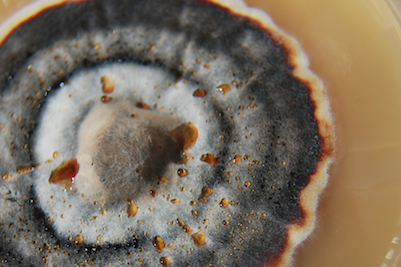
Myzel auf Petrischale

Der Lebenszyklus des Pilzes
Die meisten Menschen denken beim Wort „Pilz“ nur an die oberirdisch wachsenden Fruchtkörper, die Schwammerl. Der viel größere Teil des Pilzorganismus – in der Pilzzucht als Mycel bezeichnet - befindet sich jedoch unter der Erde. Der Pilzfruchtkörper besteht meist aus Stiel, Hut und Lamellen (Lamellenpilze – z.B. Champignon), Röhren (Röhrenpilz – z.B. Steinpilz) bzw. Poren (Porenpilze – z.B. Reishi). In den Lamellen, Röhren oder Poren werden die Sporen (Sporen sind die „Samen“ von Pilzen) gebildet. Sobald diese vollständig ausgereift sind, fallen sie aus.
Einführung in die Pilzzucht
Was sind Pilze?
Lange Zeit wurden Pilze aufgrund mangelnder Kenntnisse den Pflanzen zugeordnet. Heute wissen wir, dass der Pilz aufgrund genetischer und physiologischer Eigenschaften den Tieren näher steht als den Pflanzen. Der Hauptunterschied zu den Pflanzen ist vor allem der Umstand, dass Pilze keine Photosynthese durchführen und selbständig keine Kohlehydrate aufbauen können.
Pilze benötigen daher organische Kohlenstoffverbindungen, die von anderen Lebewesen bereitgestellt werden, um sich mit Energie zu versorgen. Somit gehören die Pilze, im organischen Stoffkreislauf des Ökosystems, zu den Destruenten. Sie bauen organisches Material ab und wandeln es in lösliche Mineralien um.
Gewinnung von Sporenabdrücken
(Schwierigkeitsstufe 2 - Fortgeschrittene)
Sporen sind die „Samen“ von Pilzen. Sie sind mikroskopisch klein und werden meistens auf der Unterseite des Pilzhutes gebildet. Sobald diese reif sind, fallen sie ab. Legt man den Hut auf ein Trägermaterial, kann man die Sporen auffangen. Das so erhaltene Muster nennt man Sporenabdruck. Dieser kann für die Züchtung neuer Pilzkulturen verwendet werden, indem man Sporen vom Abdruck auf einen geeigneten Nährboden (in der Pilzzucht ist eine Malz-Agar-Mischung in Petrischalen am gebräuchlichsten) zum Keimen aufträgt.
Mikroskopische Untersuchung von Sporen
(Schwierigkeitsstufe 1 - AnfängerIn)
Form, Farbe und Größe der Sporen sind ein nahezu unverwechselbares Merkmal zur Pilzbestimmung.
Auf dem sauberen Objektträger wird mit einer Pipette oder einer Spritze ein Tropfen Wasser aufgetragen. Mit der Impföse rührt man nun einige Sporen in das Wasser ein. Nun ist noch ein Deckglas vorsichtig aufzusetzen. Die Sporenlösung kann nun unter dem Mikroskop betrachtet werden.
Eine weitere Möglichkeit ist es, einen Tropfen aus einer Sporenspritze auf den Objektträger zu geben. Danach wieder ein Deckglas auftragen.
Herstellung eines Agar-Nährbodens in Petrischalen
(Schwierigkeitsstufe 3 – SpezialistIn)
In dieser Anleitung wird ein Rezeptvorschlag für 1 L „MEA“ (Malzextrakt-Agar-Medium) vorgestellt, das für die meisten Pilzgattungen geeignet ist. Speziell für das Arbeiten mit Sporen werden auch fertige antibakterielle Agar-Mischungen angeboten, die nur noch mit Wasser gemischt werden müssen.
Klonen von Pilzen
(Schwierigkeitsstufe 3 – SpezialistIn)
Das Klonen eines Fruchtkörpers ist eine der Methoden, Pilzmyzel zu gewinnen. Das durch Klonen gewonnene Myzel bezeichnet man als „Reinkultur“. Im Gegensatz zur „Multikultur“, bei der aus Sporen neue Organismen entstehen, ist das Myzelgeflecht jeder Reinkultur eine genetisch idente Kopie – die gezüchteten sind somit Klone der ursprünglichen Fruchtkörper.
Sterilisieren von Holzsubstraten
(Schwierigkeitsstufe 2 - Fortgeschrittene)
Die meisten Pilze bilden auf Roggensubstrat keine Fruchtkörper, weshalb mit der von Pilzmyzel besiedelten Körnerbrut ein geeignetes Fruchtungssubstrat beimpft werden muss. In dieser Anleitung stellen wir Ihnen ein Substrat vor, welches für viele holzbewohnende Pilze geeignet ist.
Myzelkultivierung aus Sporen
(Schwierigkeitsstufe 3 – SpezialistIn)
Myzelkultivierung aus Sporen ist eine Methode, um Pilzmyzel für eine „Multikultur“ zu gewinnen. Das sichtbare Myzelgeflecht einer Multikultur ist nicht ein und derselbe Pilz, wie z. B. ein Baum, sondern besteht aus vielen einzelnen Lebewesen, die aus den Sporen gekeimt sind. Infolgedessen sind die Fruchtkörper, die aus einer Multikultur entstehen, Fruchtkörper von verschiedenen eigenständigen Organismen, die gleichzeitig auf dem Fruchtungssubstrat gewachsen sind (nicht wie verschiedene Früchte von demselben Baum).
Sterilisieren von Getreidesubstrat für Körnerbrut
(Schwierigkeitsstufe 2 - Fortgeschrittene)
In der Pilzzucht wird Getreidesubstrat für die Herstellung von Körnerbrut, einer Zwischenstufe zwischen Myzel auf Agar-Nährboden und dem Fruchtungssubstrat, verwendet. Auf diese Weise können Myzelien rasch vermehrt und effizient weiterverarbeitet werden.
Beimpfen von Körnerbrut mit Myzel auf Agar-Nährboden
(Schwierigkeitsstufe 3 – SpezialistIn)
Bei diesem Arbeitsschritt muss besonders sauber und steril gearbeitet werden, damit die Körnerbrut nicht von Schimmelpilzen oder Bakterien befallen wird. Bitte vor Arbeitsbeginn die Hände und Arme gründlich waschen, Arbeitsfläche reinigen und desinfizieren. Nun legen Sie Haarnetz, Mundschutz und Latexhandschuhe an. Direkt vor Arbeitsbeginn werden nochmals die Hände desinfiziert.
Beimpfen von Holzsubstraten mit Körnerbrut
(Schwierigkeitsstufe 2 - Fortgeschrittene)
Die meisten Pilze bilden direkt auf Roggensubstrat keine bzw. wenige Fruchtkörper. Fertig von Pilzmyzel besiedelte Körnerbrut - in der Pilzzucht als 'grain' bezeichnet – wird zum Beimpfen geeigneter Fruchtungssubstrate verwendet. Vorliegende Anleitung lässt sich auf eine Vielzahl von holzbewohnenden Pilzen anwenden.
Bitte waschen Sie vor Arbeitsbeginn gründlich Hände, Unter- und Oberarme mit heißem Wasser und Seife.
„PF-Technik“
(Schwierigkeitsstufe 1 – AnfängerIn)
Die PF-Technik ist eine von Hobby-Pilzzüchtern entwickelte Methode, um mit einfachsten Mitteln Pilze zu züchten. Im Laufe der Jahrzehnte entstanden mehrere Varianten dieser Zuchttechnik. Diese Anleitung beruht auf unseren Erfahrungen.
Pilze benötigen zum Fruchten ein geeignetes Substrat. Bei der Substratherstellung soll besonders sauber bzw. steril gearbeitet werden, da ansonsten das Substrat leicht durch Schimmel oder Bakterien verunreinigt werden kann. Diese Kontaminationen machen das Substrat und die darauf wachsenden Pilze unbrauchbar.
Substratsäcke mit Sporenspritzen beimpfen
(Schwierigkeitsstufe 1 – AnfängerIn)
Diese Methode ist ähnlich einfach durchzuführen wie die PF-Technik und vor allem für Hobby-Mykologen gut geeignet. Verwenden Sie je nach Pilzgattung das passende Substrat. Detaillierte Informationen, welches Substrat für welche Pilzgattung geeignet ist, finden Sie auch in den Produktbeschreibungen unserer Sporenzüchtungen. Sobald die Sporen auf einen geeigneten Nährboden fallen, keimen sie aus. Wenn das Substrat vollständig mit Pilzmyzel besiedelt ist, kann es zum Fruchten aufgestellt werden.
Herstellung von Sporenspritzen
(Schwierigkeitsstufe 2 - Fortgeschrittene)
Sporenspritzen enthalten in sterilem Wasser gelöste Sporen, die via Injektionsnadel zum Beimpfen von Substraten verwendet werden. Vor allem für Hobby-Mykologen hat sich das Arbeiten mit Sporenspritzen bewährt, da selbst in wenig steriler Umgebung kaum Ausfälle durch Kontaminationen entstehen.
Anlegen eines Pilzbeetes
(Schwierigkeitsstufe 1 – AnfängerIn)
Ein Pilzbeet mit holzbewohnenden Pilzen anzulegen, ist sehr einfach! Als ideale Zeit gilt der Frühling, sobald kein Nachtfrost mehr zu erwarten ist. Wir empfehlen hierfür Spawn auf Holzbasis ('spawn' bezeichnet mit Pilzmyzel besiedeltes Trägermaterial, z. B. Holzsubstrat, das zum Beimpfen von Fruchtungssubstrat verwendet wird), da Körnerbrut Mäuse, Ratten und andere Schädlinge anlocken kann. Den Spawn einfach mit einem geeigneten Basismaterial vermischen und feucht halten.
Beimpfen von Baumstämmen mit Dübelbrut (Stäbchenbrut)
(Schwierigkeitsstufe 1 – AnfängerIn)
Die Anlage von Pilzkulturen auf Baumstämmen ist ganzjährig möglich, wenn der Stamm zum Durchwachsen frostfrei gelagert wird. Je nach Gattung fruchtet der Pilz mehrere Jahre hindurch, so lange, bis alle Nährstoffe aus dem Baumstamm verbraucht sind.
Die Holzqualität ist ausschlaggebend für einen guten Ertrag. Das Holz nach dem Fällen ca. 2 bis 3 Wochen trocken lagern und dann wie folgt vorbereiten:
Pilzzucht auf Strohballen
(Schwierigkeitsstufe 1 – AnfängerIn)
Für einige Pilzgattungen eignet sich auch Stroh als Fruchtungssubstrat. Es kann Weizen-, Roggen- oder Gerstenstroh verwendet werden. Besonders bewährt hat sich die Pilzzucht auf Strohballen im Garten.
Verwenden Sie nur trockene und qualitativ hochwertige (nicht schon von Schimmelpilze etc. besiedelte) Strohballen, denn sie sind ausschlaggebend für ein gutes Ergebnis. Gesundes Stroh erkennt man an der goldgelben Farbe und den festen Halmen, die sich nur schwer zerreißen lassen.
Aufbau eines Zimmergewächshaus für Pilze
Für ihr Wachstum benötigen Pilze ein geeignetes Substrat, die richtige Temperatur und Luftfeuchtigkeit, sowie ausreichend Sauerstoff und ein wenig Licht. Unsere Zuchtsets wurden speziell entwickelt, um diese Bedingungen auf möglichst einfache Weise zu gewährleisten.
Mit einfachen Mitteln kann ein handelsübliches Zimmergewächshaus zu einem Hobby-Pilzzuchtset umgebaut werden. Das Funktionsprinzip bleibt auch bei größeren Fruchtungsräumen oder –häusern gleich. Lediglich die Geräte zur Steuerung und Erzeugung der geeigneten klimatischen Bedingungen werden mit zunehmender Größe immer raffinierter.